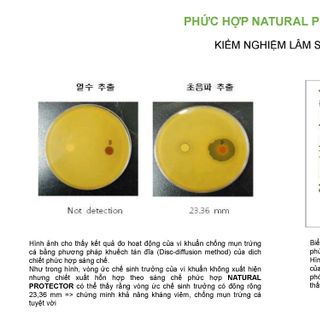
SỮA RỬA MẶT TRẮNG DA CHO DA DẦU, DA MỤN, DA HỖN HỢP GEL CLEANSER

SỮA RỬA MẶT TRẮNG DA CHO DA DẦU, DA MỤN, DA HỖN HỢP GEL CLEANSER giá sỉ - giá bán buôn
550.000₫
1 - 2 Chai
490.000₫
3 - 9 Chai
460.000₫
≥ 10 Chai
Có thể thương lượng
Mua ít nhất: 1 Chai
Tồn kho 1.000
Đảm bảo thanh toán Đảm bảo về hàng hóa
Để hỏi về giá sản phẩm, sản phẩm liên quan hoặc các thông tin khác:
Sản phẩm841
Người theo dõi123
Lượt liên hệ335
Tỷ lệ phản hồi100%
SỮA RỬA MẶT TRẮNG DA CHO DA DẦU, DA MỤN, DA HỖN HỢP GEL CLEANSER
Sữa rữa mặt chuyên biệt dành cho da dầu , mụn, hỗn hợp
Thể tích: 100ml
Xuất xứ: Hàn Quốc
Phân phối: Damode VN
Tên nhà cung cấp:
Kho Hàng Sỉ Skyhouse
Địa chỉ:
Q. Tân Bình, TP Hồ Chí Minh
Tham gia từ:
2018
Đề xuất từ cửa hàng
Sản phẩm tương tự
Bạn cũng có thể thích
Sản phẩm đã xem
Chưa tìm được thứ bạn cần? Hãy để nhà cung cấp liên hệ đến bạn
Gửi 1 yêu cầu báo giá, nhận nhiều lượt báo giá từ hơn 60,000 nhà cung cấp
Bạn có biết: Tìm sản phẩm để mua sỉ trên Google nhanh hơn với cú pháp: tên sản phẩm + thitruongsi. Ví dụ: áo thun trơn giá sỉ thitruongsi
